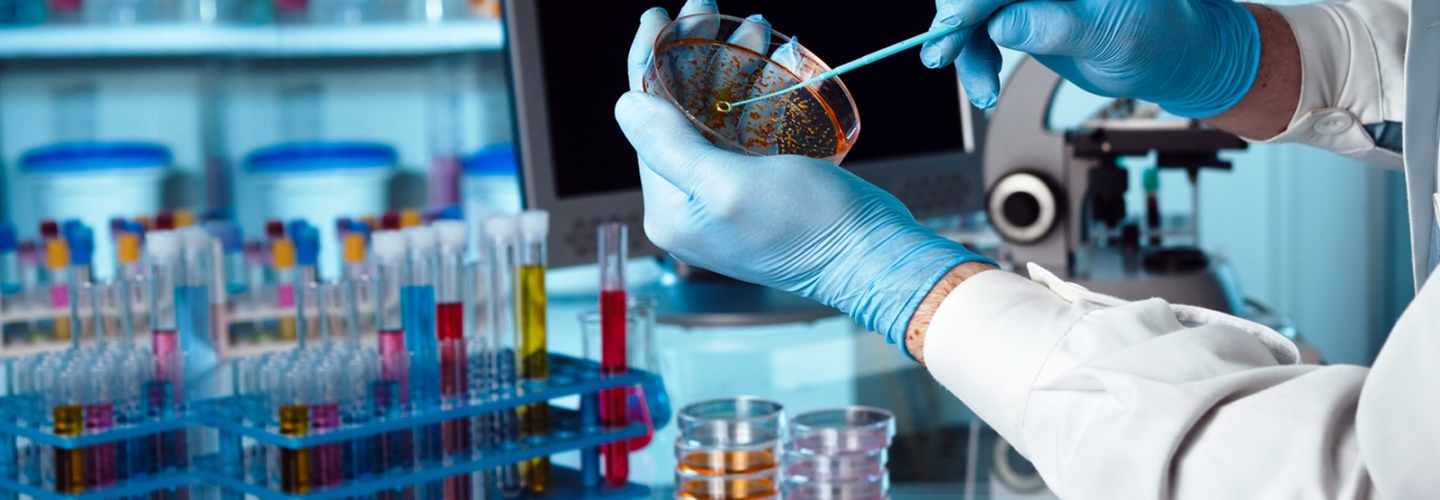
slider

Wellchem Laboratories was incorporated in the year 1985 in Navi Mumbai, in the state of Maharashtra, India. Initially, our company manufactured Bulk Drugs and Pharmaceuticals additives and in the course of time,we started manufacturing intermediates and specialty chemicals such as Grignards and perform reactions like Esterification, solvent extraction, vacuum distillation etc. Read More
We have developed products used in various industries like pharmaceutical, cosmetics, etc. in the last three decades. We have ensured that the products manufactured and the services provided are consistent with good quality and acceptable standards and customer requirements while enhancing process efficiency.